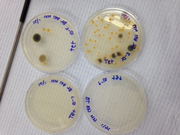

Uploads by Adam Nolan
From OpenWetWare
Jump to navigationJump to search
This special page shows all uploaded files.
| Date | Name | Thumbnail | Size | Description |
|---|---|---|---|---|
| 05:26, 9 March 2015 | 270px-Control Day 8.png (file) |  |
44 KB | |
| 05:24, 9 March 2015 | 270px-Test Day 8.png (file) |  |
43 KB | |
| 05:23, 9 March 2015 | Control Day 15.png (file) |  |
62 KB | |
| 05:22, 9 March 2015 | Control Day 13.png (file) |  |
77 KB | |
| 05:21, 9 March 2015 | 270px-IndivControl Day 10.png (file) |  |
82 KB | |
| 05:21, 9 March 2015 | 270px-IndivTest Day 10.png (file) |  |
83 KB | |
| 04:43, 1 March 2015 | Electro13.png (file) |  |
28 KB | |
| 03:01, 1 March 2015 | PLanmtz.png (file) |  |
50 KB | |
| 00:12, 1 March 2015 | Screenie.png (file) |  |
18 KB | |
| 23:56, 28 February 2015 | Plant table.png (file) |  |
85 KB | |
| 01:01, 28 February 2015 | Tet .png (file) | |
125 KB | |
| 01:00, 28 February 2015 | Agar.png (file) |  |
121 KB | |
| 00:53, 28 February 2015 | Bacteriaaa.png (file) |  |
52 KB | |
| 00:39, 28 February 2015 | Tayble.png (file) |  |
36 KB | |
| 00:31, 28 February 2015 | Jar view.png (file) |  |
146 KB | |
| 00:24, 28 February 2015 | Cell 1.png (file) |  |
125 KB | |
| 00:15, 28 February 2015 | CELL.png (file) |  |
4.75 MB | |
| 00:07, 28 February 2015 | Cell 5.png (file) |  |
1.97 MB | |
| 00:05, 28 February 2015 | Cell 4.png (file) |  |
1.55 MB | |
| 00:02, 28 February 2015 | Cell 3.png (file) |  |
1.97 MB | |
| 00:00, 28 February 2015 | Cell 2.png (file) |  |
1.94 MB | |
| 22:26, 27 February 2015 | Transect Sketch.png (file) |  |
304 KB | |
| 22:23, 27 February 2015 | Transect sketch.pdf (file) | 155 KB | ||
| 22:19, 27 February 2015 | Adam Nolan Transect LAB 1.pdf (file) | 102 KB | Reverted to version as of 03:32, 28 January 2015 | |
| 19:29, 4 February 2015 | Lab 3 Bacteria.pdf (file) | 148 KB | ||
| 04:17, 28 January 2015 | Adam Nolan Hay Infusion LAB 2.pdf (file) | 108 KB | ||
| 03:18, 28 January 2015 | Adam Nolan Transect LAB 1.docx (file) | 12 KB |